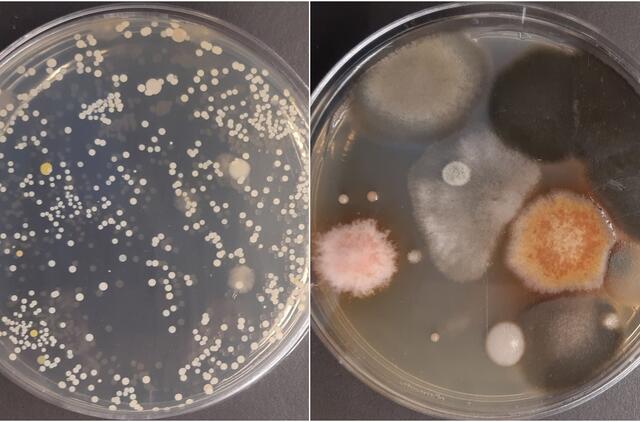

Mokslininkė ištyrė paštomatų paviršius – perspėja, kad didžioji jų dalis perpildyta mikrobais
Tačiau neseniai Lietuvoje atliktas tyrimas parodė, kad nemažiau mikrobų knibžda ir ant paštomatų, o tiksliau jų ekranų, paviršiaus.
Artėjant bene intensyviausiam šventiniam, o tuo pačiu ir pirkimų laikotarpiui, patariama atidžiai rinktis ne tik paštomatus, bet ir nepamiršti apie rankų dezinfekciją ar kitas papildomas saugos priemones.
Bakterijos aptiktos ant visų liečiamų paštomatų paviršių
Viso tyrimo metu buvo ištirta 11-os paštomatų, esančių skirtingose sostinės vietose, paviršiai. Paimtų mėginių rezultatai, pasak VU Gyvybės mokslų centro tyrėjos dr. Renatos Gudiukaitės nestebina, kadangi visi šie paštomatai lokalizuoti didelius žmonių srautus pritraukiančiuose prekybos centruose ar parduotuvėse ir priklauso kurjerių paslaugas teikiančioms įmonėms, kurių paslaugomis visuomenė naudojasi dažniausiai.
„Tyrimas parodė, kad mikrobiologinė tarša – pelėsiai, bakterijos, galime numanyti, kad ir virusai – būdingi absoliučiai daugumai liečiamus paviršius turinčių paštomatų. Jos lygis tiesiogiai susijęs su lokacija – didžiausia koncentracija fiksuojama ten, kur praeina didžiausi žmonių srautai.
Paprastai šnekant, kuo prekybos vieta didesnė, tuo daugiau žmonių ja naudojasi ir atitinkamai palieka didžiausią žymę ant paštomatų“, – pasakoja tyrėja.
Dr. R. Gudiukaitė atkreipia dėmesį, jog norint tiksliai identifikuoti tiriamoje aplinkoje nustatytus mikroorganizmus ir spėti apie jų pavojų žmogaus sveikatai, reikalingi papildomi molekulinės prokariotų taksonomijos ir molekulinės biologijos tyrimai, tačiau pabrėžia, jog norint užtikrinti aplinkos švarą ir visuomenės saugumą, būtina skirti laiko ir resursų paštomatų ekranų, kaip vienų iš dažniausiai žmonių liečiamų aplinkos paviršių, dezinfekcijai.
Siūlo imtis papildomų saugumo priemonių arba ieškoti alternatyvų
Naudojantis paštomatais, pasak dr. R. Gudiukaitės, galioja tos pačios taisyklės kaip ir kitose viešosiose vietose: patariama dėvėti vienkartines pirštines, dezinfekuoti rankas, o jei įmanoma – ir patį paštomato ekraną. Išsiuntus ar atsiėmus siuntinį taip pat rekomenduojama kruopščiai nusiplauti rankas muilu, neliesti veido ar, pavyzdžiui, žaizdelių turinčių odos vietų – tokiu būdu išvengiama pavojingų mikroorganizmų įnešimo į organizmą.
„Žinoma, dauguma sakys, kad mes su šiais mikroorganizmais susiduriame nuolat ir jokio pavojaus nėra, vis dėl to, šaltuoju orų sezonu, nusilpus imunitetui, didėjant kvėpavimo takų susirgimų rizikai, tokie „nekalti“ mikroorganizmai gali tapti dar vienu infekcijų šaltiniu. Papildoma apsauga šioje situacijoje tikrai duos daugiau naudos nei padarys žalos “, – teigia mokslininkė.
Tiesa, viena siuntų tarnybos įmonė rinkoje jau kurį laiką išsiskiria siūlydama bekontakčių paštomatų paslaugą. Siuntai pasiekus paštomatą, pirkėjai gauna SMS žinutę su nuoroda į QR kodą, o norint atsiimti siuntą, užtenka šį parodyti priešais kamerą – durelės atsiveria pačios.
„Tokia technologija leidžia išvengti įprasto lietimosi prie paštomato, be to, taupo laiką, kurį įprastai praleidžia vartotojai, maigydami komandas paštomato ekrane.
Esame paskaičiavę, kad siuntos atsiėmimo laikas sutrumpėja nuo 30-45 iki 3-5 sekundžių“, – pasakoja inovaciją pristačiusios įmonės „Venipak“ vadovas Justas Šablinskas.
– Inicijuoti bekontakčių paštomatų tinklą mus ypatingai paskatino e-komerciją vykdančių verslų pastebėjimai, jog jų paslaugomis besinaudojantys pirkėjai vis dažniau renkasi nebe pristatymą iki durų, o savarankišką siuntų atsiėmimą paštomatuose.
Tokia saugi paštomatų alternatyva, jo teigimu, pandemijos akivaizdoje pasiteisino dvigubai, mat vartotojams saugumas tapo ne ką mažiau svarbus nei operatyvumas.


































Rašyti komentarą